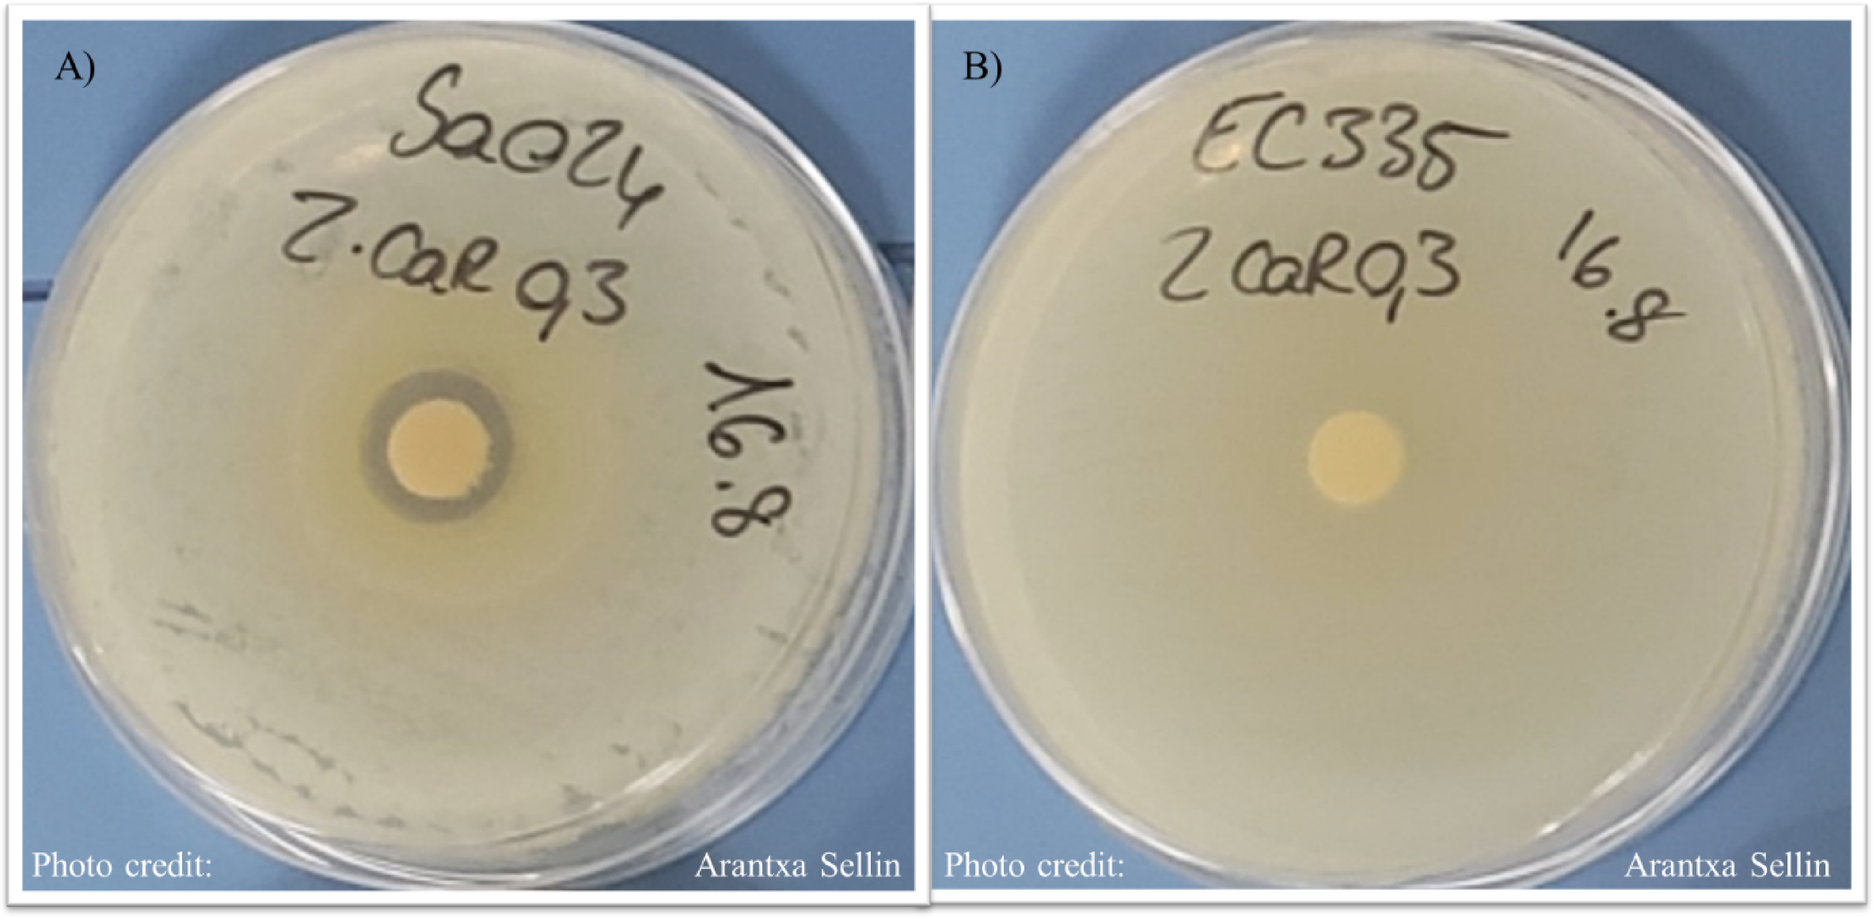
Fig. 2

Fig. 2

Representative disk diffusion assay results for Z. caribaeum aqueous extract. (A) Activity against Staphylococcus aureus and (B) Activity against Escherichia coli isolates.
Representative disk diffusion assay results for Z. caribaeum aqueous extract. (A) Activity against Staphylococcus aureus and (B) Activity against Escherichia coli isolates.